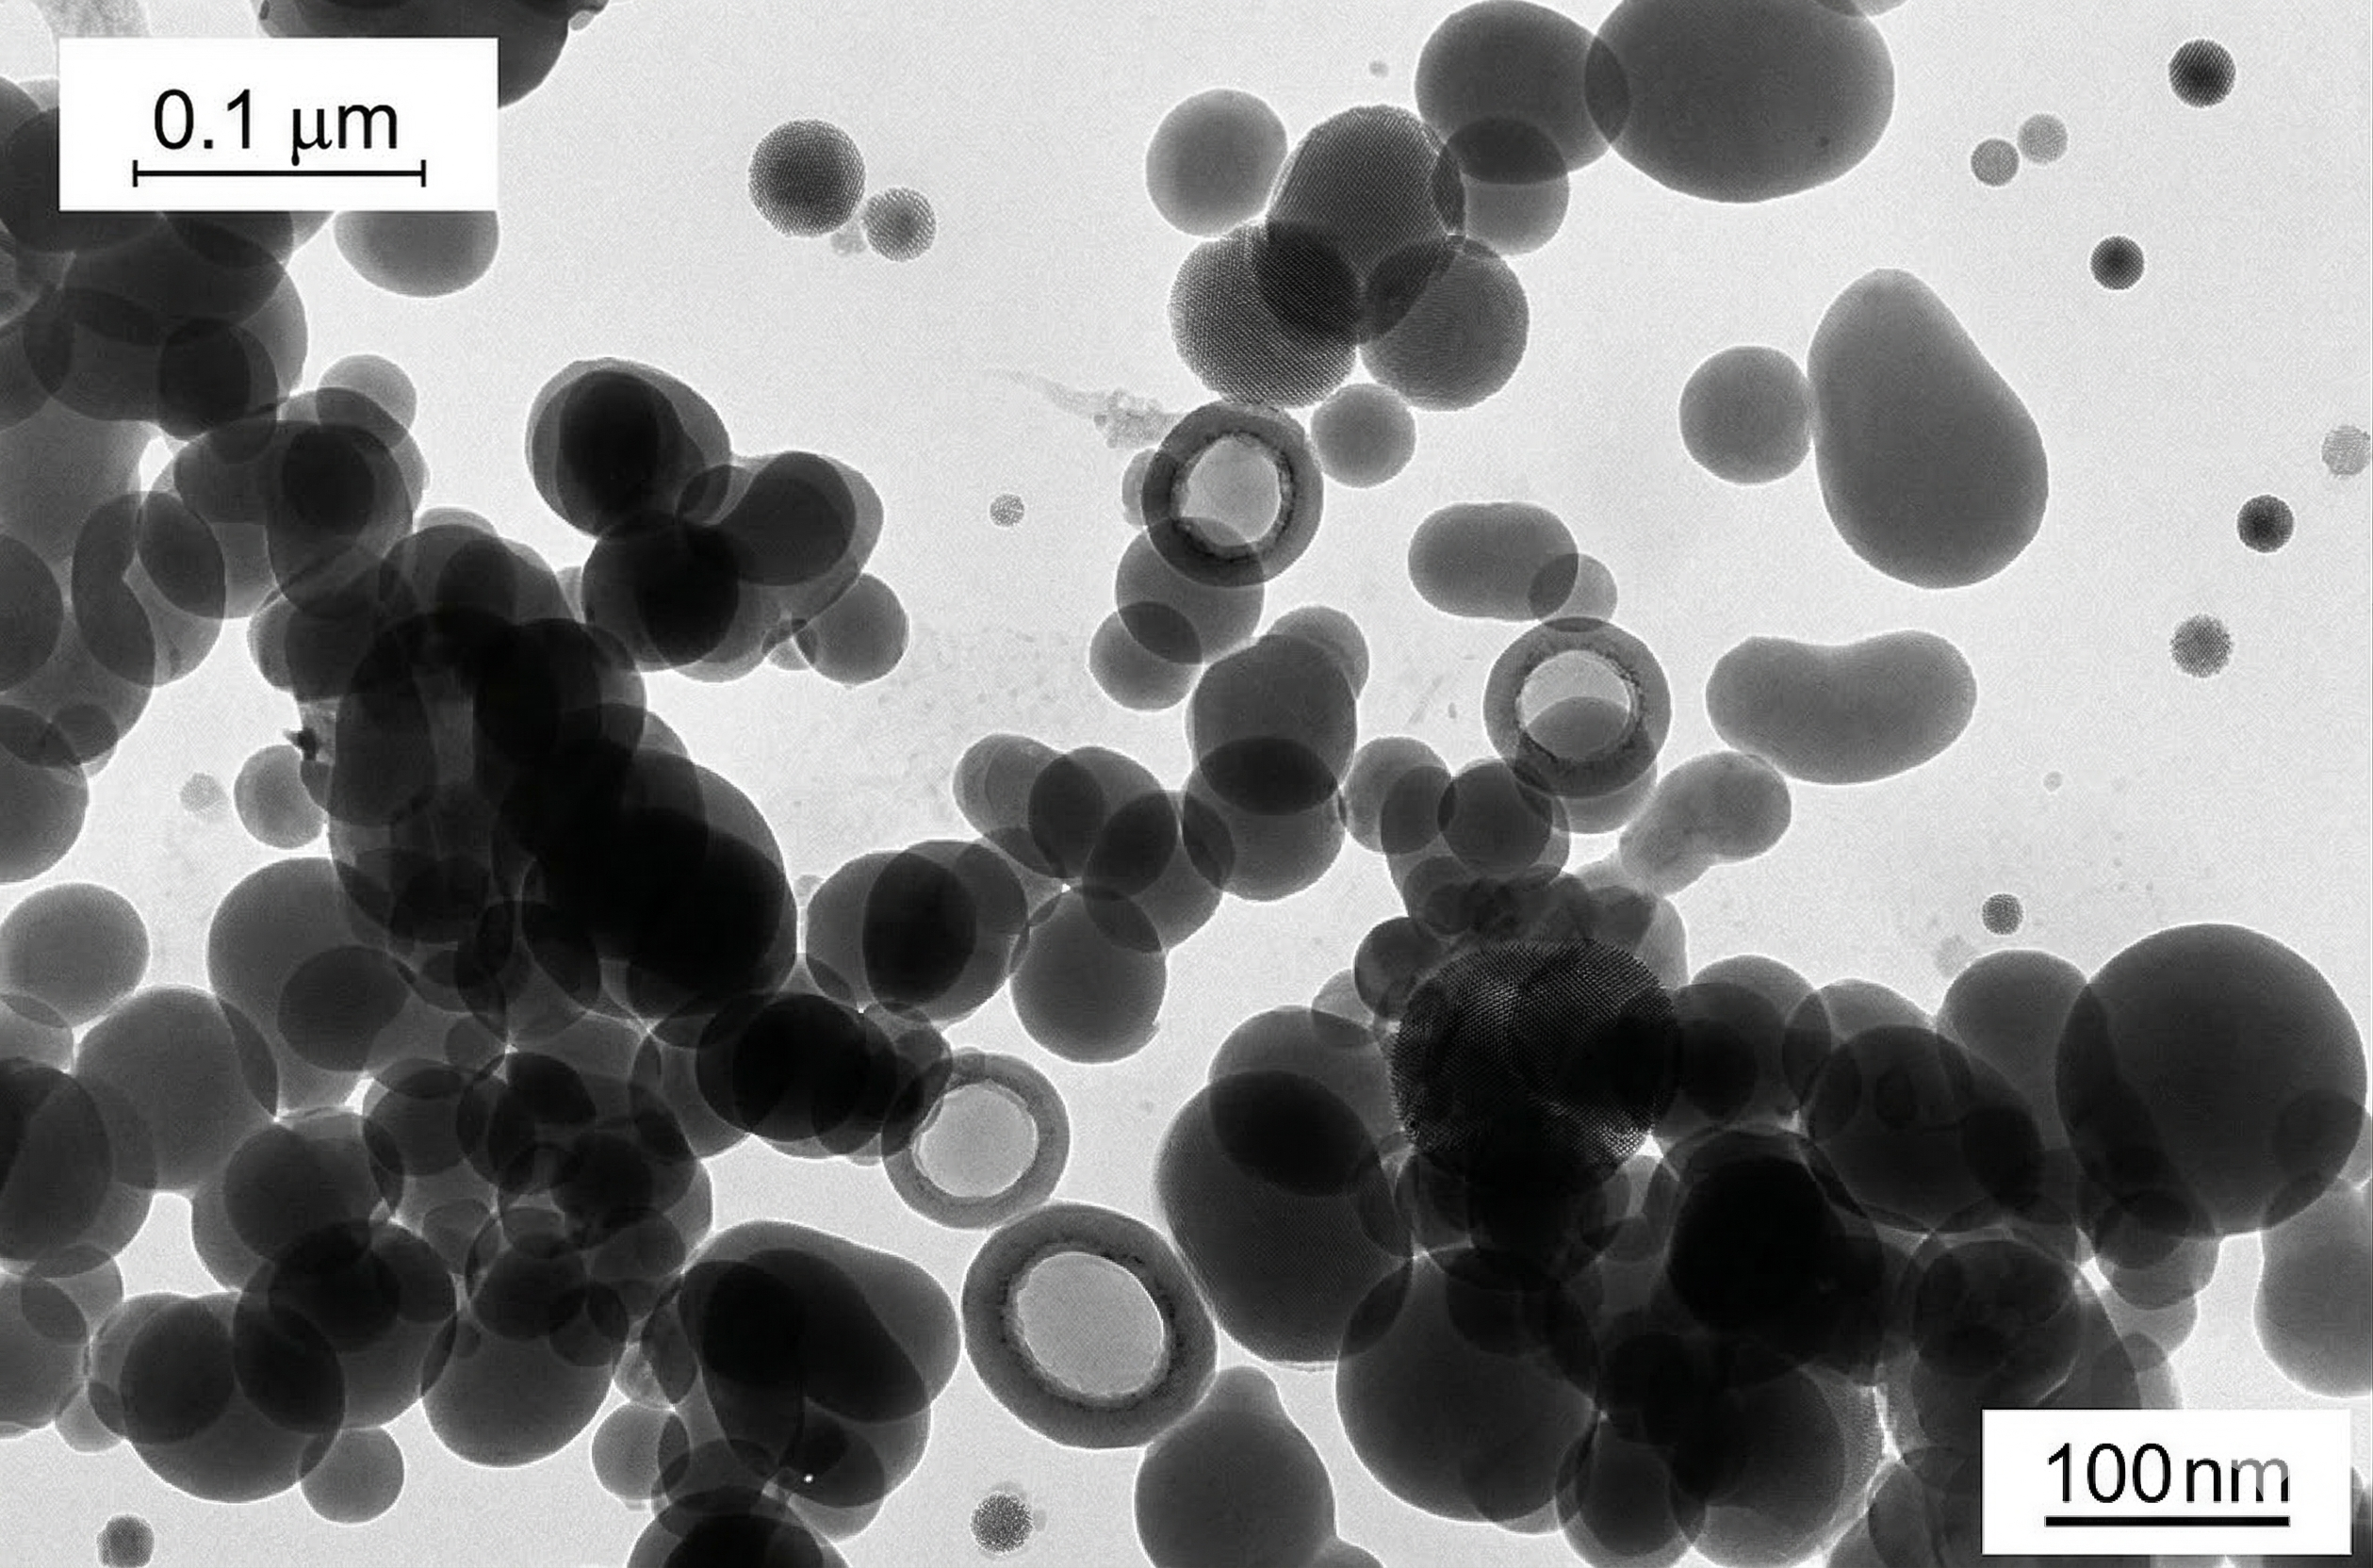
TEM Image of Fumed Silica showing 0.1 micron scale fused aggregate chains

Shanghai Semitech New Material Co., Ltd.
1628 Lijing Road, Lingang New Area, 200000, Shanghai, China.
Mobile:
+8615639100440
Email:
info@semitechnm.com
Shanghai Semitech New Material Co., Ltd.
1628 Lijing Road, Lingang New Area, 200000, Shanghai, China.
Mobile:
+8615639100440
Email:
info@semitechnm.com
Everything you need to know about fumed silica: how it's made, why it works, and where it's used. Built for engineers, formulators, and procurement professionals.
SiCl₄ + 2H₂ + O₂ → SiO₂ + 4HClA synthetic, ultra-pure amorphous silicon dioxide made by burning SiCl₄ in a hydrogen flame at over 1500 °C.
Fumed silica — also called pyrogenic silica — was first commercialized in 1944 by Degussa (now Evonik) under the AEROSIL® brand. Nanoscale primary particles, extremely high surface area, and zero porosity make it one of the most versatile functional additives in materials science.
Looks like fresh snow — ultra-light, fluffy white powder. Bulk density can be as low as 20 g/L. Becomes airborne with the slightest air current.

Fig 1 — Pure fumed silica powder.
Fig 2 — Texture detail, 130 m²/g grade.
Vaporized SiCl₄ enters a hydrogen–oxygen flame (>1500 °C) inside a burner reactor. The SiO₂ formed is cooled, separated by cyclone filters, deacidified, and packaged. The HCl byproduct is recovered for reuse.

Fig 3 — Flame hydrolysis: from SiCl₄ feed to agglomerate product.
Every performance property traces back to this three-level structure. Understanding it is the key to selecting the right grade.
| Level | Size | Bond | Reversible? |
|---|---|---|---|
| Primary Particle | 7–40 nm | Covalent (bulk SiO₂) | No |
| Aggregate | 100–500 nm | Sinter bridges (Si–O–Si) | No |
| Agglomerate | 1–200 µm | Hydrogen bonds (Si–OH⋯OH–Si) | Yes |
Aggregates are the functional unit — permanent chains that give fumed silica its thickening and reinforcing power. Agglomerates break apart under shear and re-form at rest — the origin of thixotropy.
| Property | Value |
|---|---|
| Bulk density (untamped) | 20–60 g/L |
| pH (4% in water) | 3.7–4.5 |
| Loss on drying (105 °C, 2h) | <1.5 wt% |
| Loss on ignition (1000 °C, 2h) | <2.0 wt% |
| Silanol density | ~2–3 OH/nm² |
| Refractive index | 1.46 |
Surface silanol groups (Si–OH) drive hydrophilicity, hydrogen-bond networking, and polymer interaction. Hydrophobic grades replace –OH with –CH₃ for non-polar systems.
Thickening, thixotropy, anti-sag in coatings, adhesives, sealants, inks, UPE resins.
Tensile strength, tear resistance, hardness in HTV/RTV silicone rubber.
0.1–1% loading coats particles, reduces cohesion. Pharma, food, toner.
Weak gel suspends pigments in storage. Re-liquefies under stirring.
VIP core material. Achieves <0.005 W/(m·K) thermal conductivity.
Thickens electrolytes in lead-acid and Li-ion batteries. Prevents leakage.
| Parameter | Fumed | Precipitated |
|---|---|---|
| Process | Gas-phase flame hydrolysis | Wet chemical precipitation |
| SiO₂ purity | >99.8% | ~85–98% |
| Particle structure | Non-porous spheres | Porous, irregular |
| Moisture / LOI | <1.5% / <2% | ~5% / ~5–8% |
| Silanol density | ~2–3 OH/nm² | ~4–6 OH/nm² |
| Thickening efficiency | High (lower dose) | Moderate |
| Transparency | Excellent | Lower |
| Cost | Higher | Lower |
No. Fumed silica = high-purity synthetic product (flame hydrolysis). Silica fume = byproduct of silicon smelting, used in concrete. Entirely different materials.
Amorphous, not a carcinogen. But ultra-fine particles can irritate lungs/eyes. Use dust masks, safety glasses, enclosed systems. Follow the SDS.
Silicone: 150–200 m²/g. Coatings: 150–300 m²/g. Flow aid: 200+ m²/g. Higher surface = stronger effect, harder to disperse.
Hydrophilic grades: yes — forms thixotropic gels above ~3–5 wt%. Hydrophobic grades: SEMISIL R272, R110, R202, R620.
We use cookies to improve your experience on SEMITECH. By continuing, you agree to our Privacy Policy and Terms of Service.
